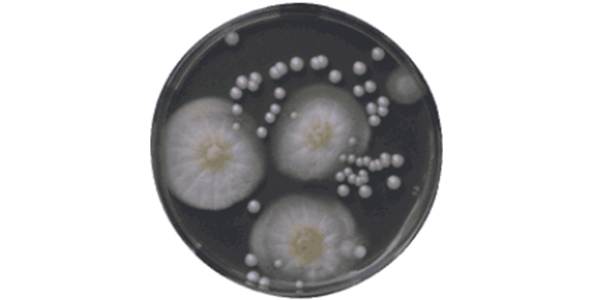
Reaģenti medicīnai un mikrobioloģijai

ENOLA, SIA
Pamatdati
| Statuss | Aktīvs
|
|---|---|
| Uzņēmējdarbības forma | Sabiedrība ar ierobežotu atbildību |
| Reģistrēts nosaukums | Sabiedrība ar ierobežotu atbildību "ENOLA" |
| Reģistrācijas numurs, datums | 40103049886, 07.05.1992 |
| PVN numurs | LV40103049886 ar 31.05.1995 Pārbaudīt VID tiešsaistē PVN maksātājus |
| Eiropas PVN reģistrs | |
| Reģistrs, datums | Komercreģistrs, 19.10.2004 |
| Juridiskā adrese | Aizkraukles iela 23, Rīga, LV-1006 Pārbaudīt adreses īpašniekus |
| Pamatkapitāls | 2 840 EUR, reģistrēta apmaksa 27.04.2016 |
| CSDD | CSDD reģistrētie transportlīdzekļi |
Vairāk par uzņēmumu
| Faktiskā adrese | Aizkraukles 23, Rīga, LV-1006 |
|---|---|
| Tālrunis | +371 67372566 |
| Mobilais tālrunis | +371 29236869 |
| E-pasts | info@enola.lv |
| Valdes loceklis | Jānis Ģībietis |
| www.facebook.com/Enola-ķīmijas-sabiedrība-2150794445235446 | |
| Mājaslapa | www.enola.lv |
| GBP | Google meklēšanas rezultātos |
| LinkedIn.com | www.linkedin.com/company/sia-enola |
| www.instagram.com/enola_kimijas/ | |
| Darba laiki |
P. 9:00-16:00
O. 9:00-16:00
T. 9:00-16:00
C. 9:00-16:00
Pk. 9:00-16:00
S. Brīvs
Sv. Brīvs
|
| Nozare | Ķīmiskie reaģenti, Laboratorijas iekārtas un piederumi |
| Apraksts | Ķīmijas sabiedrība "Enola" ir Rīgā dibināts uzņēmums, kas kopš 1992. gada specializējas laboratoriju apgādē ar reaģentiem, laboratorijas traukiem un laboratorijas aparatūru. Uzņēmuma darbība aptver dažādu profilu laboratorijas – analītiskās, fizikālās un sintētiskās ķīmijas laboratorijas, kā arī bioķīmijas, mikrobioloģijas un klīniskās diagnostikas laboratorijas. "Enola" piedāvā ķīmiskos reaģentus, reaģentus medicīnai un mikrobioloģijai, laboratorijas traukus no stikla, porcelāna un plastmasas, laboratorijas aparātus un laboratorijas iekārtas. Sortimentā pieejami arī mācību līdzekļi un molekulu modeļi. Pakalpojumi
Kāpēc izvēlēties "Enola"?
|
| Pakalpojumi | Uzņēmums nodrošina laboratoriju apgādi ar laboratorijas materiāliem un aprīkojumu profesionālai lietošanai.... skatīt vairāk |
| Kāpēc izvēlēties "Enola"? | "Enola" klienti novērtē ilggadēju pieredzi, stabilu produktu pieejamību un profesionālu pieeju laboratoriju... skatīt vairāk |
Svarīgākie fakti
- Nav aktīvu komercķīlu
- Nav nodrošinājumu
- Nav apturēta saimnieciskā darbība
- Nav darbības ierobežojumu
- Strādā ar peļņu
- Skatīties AML riskus
- Nav ieraksti maksātnespējas reģistrā
- Nav likvidācijas procesa
- Nav reorganizācijas procesu
- Ir kontaktdati
- Pozitīvs pašu kapitāls
- Pārbaudīt tiešsaistē VID aktuālo nodokļu samaksu
- Nav parādu piedziņas lietu
- VID nodokļu maksātāju reitings B - Jāuzlabo saistību izpilde
Attēlu galerija
Preču zīmes
Informācijas produkti
Pilna izziņa par uzņēmumu

Vienas dienas piekļuve

Patiesie labuma guvēji
| Patiesais labuma guvējs | Laiks | Pastāvīgās dzīves vietas valsts | Valsts piederība |
|---|---|---|---|
| Fiziska persona | No 11.07.2019 | Latvija | Latvija |
|
Kontroles veids: kā dalībnieks |
|||
Amatpersonas
| Vārds | Institūcija | Amats | Pārstāvības/paraksta tiesības | Piezīmes | No* |
|---|---|---|---|---|---|
Fiziska persona |
Valde | Valdes loceklis | Tiesības pārstāvēt atsevišķi | 22.03.2012 |
Dalībnieki
| Nosaukums, adrese | Daļa, % | Daļu skaits | Daļas vērtība | Kopsumma | Valsts | No | Reģistrēts UR |
|---|---|---|---|---|---|---|---|
Fiziska persona |
100 % | 10 | € 284 | € 2 840 | 04.04.2016 | 27.04.2016 |
Nodokļu maksājumi valsts kopbudžetā
| VID nodokļu maksātāju reitings |
B
Jāuzlabo saistību izpilde. Uzņēmums kopumā pilda savas saistības ar valsti, tomēr te ir vieta uzlabojumiem – laicīgi iesniegt deklarācijas, deklarēt un laikus samaksāt visus nodokļus.
|
||
|---|---|---|---|
| 2024 | 2023 | 2022 | |
| Kopējie maksājumi valsts kopbudžetā (tūkst. €) | 55.69 | 62.13 | 64.83 |
| Iedzīvotāju ienākuma nodoklis (tūkst. €) | 5.76 | 7.50 | 8.13 |
| Valsts sociālās apdrošināšanas obligātās iemaksas (tūkst. €) | 16.05 | 18.09 | 17.89 |
| Vidējais darbinieku skaits | 5 | 5 | 5 |
| Gads | Kvartāls | Kopējie maksājumi valsts kopbudžetā (tūkst. €) |
Iedzīvotāju ienākuma nodoklis (tūkst. €) |
Valsts sociālās apdrošināšanas obligātās iemaksas (tūkst. €) |
Vidējais darbinieku skaits |
|---|---|---|---|---|---|
| 2026 | 1 | 13.53 | 8.64 | 3.77 | 4 |
| 2025 | 4 | 14.63 | 9.91 | 3.65 | 4 |
| 2025 | 3 | 12.16 | 6.66 | 4.19 | 5 |
| 2025 | 2 | 11.05 | 6.71 | 3.39 | 4 |
| 2025 | 1 | 13.34 | 8.36 | 3.9 | 5 |
Nozares
| Nozare no zl.lv | Ķīmiskie reaģenti |
|---|---|
| Nozare no zl.lv (NACE2)
Redakcija NACE 2.1 |
Citur neklasificētu ķīmisku produktu ražošana (20.59) |
| Nozare no VID
Redakcija NACE 2.1 |
Ķīmisku produktu vairumtirdzniecība (46.85) |
| Nozare no CSP
Redakcija NACE 2.1 |
Ķīmisku produktu vairumtirdzniecība (46.85) |
Vēsturiskās adreses
| Rīga, Krišjāņa Valdemāra iela 48 | līdz 28.09.2018 | pirms 8 gadiem |
|---|
Gada pārskati
| Gads | Periods | Saņemts | Piegādes veids | Cena | |
|---|---|---|---|---|---|
2025 |
Gada pārskats | 01.01.2025 - 31.12.2025 | 20.05.2026 | PDF (463.07 KB) | |
2024 |
Gada pārskats | 01.01.2024 - 31.12.2024 | 30.05.2025 | PDF (116.63 KB) | €7.00 |
2023 |
Gada pārskats | 01.01.2023 - 31.12.2023 | 27.05.2024 | PDF (79.45 KB) | €11.00 |
2022 |
Gada pārskats | 01.01.2022 - 31.12.2022 | 21.05.2023 | PDF (443.66 KB) | €11.00 |
2021 |
Gada pārskats | 01.01.2021 - 31.12.2021 | 20.05.2022 | PDF (79.43 KB) | €11.00 |
2020 |
Gada pārskats | 01.01.2020 - 31.12.2020 | 28.04.2021 | PDF (79.47 KB) | €11.00 |
2019 |
Gada pārskats | 01.01.2019 - 31.12.2019 | 05.05.2020 | PDF (450.96 KB) | €11.00 |
2018 |
Gada pārskats | 01.01.2018 - 31.12.2018 | 18.04.2019 | PDF (78.3 KB) | €11.00 |
2017 |
Gada pārskats | 01.01.2017 - 31.12.2017 | 18.04.2018 | PDF (626.43 KB) | €11.00 |
2016 |
Gada pārskats | 01.01.2016 - 31.12.2016 | 29.04.2017 | PDF (799.21 KB) | €9.00 |
2015 |
Gada pārskats | 01.01.2015 - 31.12.2015 | 04.05.2016 | ZIP | €8.00 |
| Gada pārskats 2015 | |||||
| GP2016 paskaidrojums | |||||
2014 |
Gada pārskats | 01.01.2014 - 31.12.2014 | 29.04.2015 | ZIP | €7.00 |
| 1_HTML izdruka | HTML | ||||
| enola protokols | JPG | ||||
2013 |
Gada pārskats | 01.01.2013 - 31.12.2013 | 29.04.2014 | ZIP | |
| 1_HTML izdruka | HTML | ||||
| 2013.Vadibas zinojums | |||||
2012 |
Gada pārskats | 01.01.2012 - 31.12.2012 | 25.04.2013 | ZIP | |
| 1_HTML izdruka | HTML | ||||
| 2012.Vadibas zinojums | |||||
2011 |
Gada pārskats | 01.01.2011 - 31.12.2011 | 25.04.2012 | ZIP | |
| 1_HTML izdruka | HTML | ||||
| 2011.Vadibas zinojums | |||||
2010 |
Gada pārskats | 01.01.2010 - 31.12.2010 | 30.04.2011 | ZIP | |
| 1_HTML izdruka | HTML | ||||
| Vadibas zinojums2010 | RTF | ||||
2009 |
Gada pārskats | 07.06.2010 | TIF (628.03 KB) | ||
2008 |
Gada pārskats | 20.05.2009 | TIF (616.16 KB) | ||
2007 |
Gada pārskats | 10.02.2009 | TIF (239.56 KB) | ||
2006 |
Gada pārskats | 25.06.2007 | TIF (533.73 KB) | ||
2005 |
Gada pārskats | 21.11.2006 | TIF (159.78 KB) |
Dokumenti
| Veids | Formāts | Izmērs | Pievienots | Dokumenta datums | Lapu skaits |
|---|---|---|---|---|---|
Statūtu grozījumi |
150.91 KB | 22.04.2016 | 22.04.2016 | 1 | |
Statūti |
74.78 KB | 22.04.2016 | 04.04.2016 | 1 | |
Dalībnieku reģistrs |
1.59 MB | 22.04.2016 | 04.04.2016 | 2 | |
Dalībnieku reģistrs |
34.95 KB | 22.04.2016 | 01.04.2016 | 1 | |
Dalībnieku reģistrs |
TIF | 17.45 KB | 23.03.2012 | 10.01.2012 | 1 |